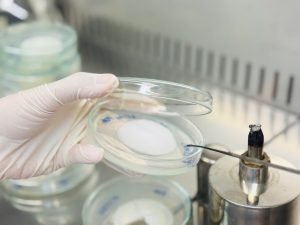

Chủ nhật, 24-05-2026
Kiểm nghiệm viên Trung tâm Khảo kiểm nghiệm Phân bón Quốc gia tích cực phát huy nghề, phân lập, lưu trữ và nuôi cấy nấm có ích để ứng dụng trong chuỗi nông nghiệp tuần hoàn hữu cơ và chuyển giao tới các Doanh nghiệp ứng dụng công nghệ cao!
07/12/2025

- Công ty Ecohopia – Hàn Quốc tới thăm và làm việc tại Trung tâm Khảo kiểm nghiệm phân bón Quốc gia
- Trồng thành công sâm Hàn Quốc theo hướng hữu cơ tại Vĩnh Phúc
- Trung tâm Khảo kiểm nghiệm Phân bón Quốc gia hợp tác liên kết Bình Xuyên – Hightech chuyển giao các giải pháp kỹ thuật, công nghệ ứng dụng vi sinh trong sản xuất phân bón hữu cơ, chăn nuôi, thuỷ sản, môi trường, cảu tạo đất, trồng Nhân sâm, Wasabi tại Vĩnh phúc
- Công ty TNHH Nông Lâm Nghiệp Ứng Dụng Công nghệ cao Bình Xuyên áp dụng công nghệ AI vào việc trồng nhân sâm Hàn Quốc
- Đoàn công tác của Hàn Quốc thăm mô hình nông nghiệp Công nghệ cao do Trung tâm Khảo kiểm nghiệm phân bón Quốc gia chuyển giao công nghệ trồng nhân sâm Hàn Quốc cho công ty TNHH Nông Lâm Nghiệp ứng dụng Công Nghệ Cao Bình Xuyên tại huyện Bình Xuyên tỉnh Vĩnh Phúc
- Quyết định 3745/QĐ-TTTV-KHCN ngày 27/10/2025 của Cục Trồng trọt và Bảo vệ thực vật, về việc ủy quyền thực hiện kiểm tra nhà nước chất lượng phân bón nhập khẩu
- Nghị định 130/2022/NĐ-CP ngày 31/12/2022, sửa đổi, bổ sung một số điều của Nghị định số 84/2019/NĐ-CP ngày 14 tháng 11 năm 2019
- Nghị định 84/2019/NĐ-CP ngày 14/11/2019 quy định về quản lý phân bón
- Nghị định 31/2023/NĐ-CP ngày 9/6/2023, quy định xử phạt vi phạm hành chính về Trồng trọt
- Luật Trồng trọt số 31/2018/QH14 ngày 22/12/2018


